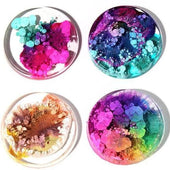

- It will create a beautiful effect on all your Art projects.
- 15 bottles Alcohol Inks pigment set with sealed bottled package, each bottle contains 10 ml.
- Easy to Use: The special designed nozzle can help control the amount color you drop until you achieve the color you want.
- Colors - White, Black, Blue, Sky Blue, Sapphire Blue, Green, Lemon Green, Yellow, Orange, Brown, Violet, Purple, Red, Sunset, Peach
-
Flammable: Do not not torch with flame as product contains alcohol.
Any questions? Give us a call (905) 370-1111
- Reviews
- Shipping
- Calculator
- Free shipping in Canada & USA on all orders over $50.
- All orders placed Monday to Friday by 4:00 pm EST are shipped the same day.
- All orders will be delivered in 1-3 business days to most Canadian provinces.
- More details here
Not sure how much epoxy resin you need to get started? Input your project details into our Resin Calculator for personalized recommendations.
Length (in)
Width (in)
Depth (in)
Custom Depth (in)
- Choosing a selection results in a full page refresh.
- Press the space key then arrow keys to make a selection.